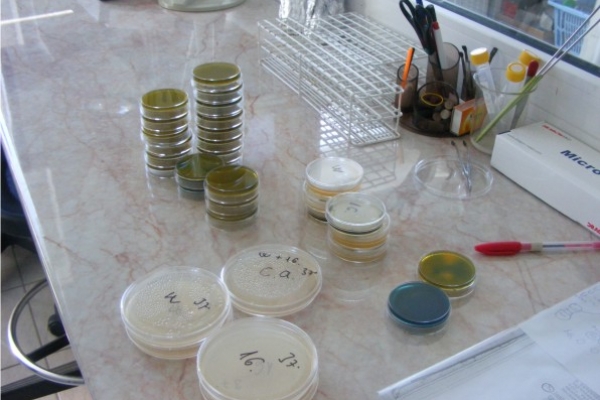
mikrobiologia405569241-855B-BC57-A447-14F1A4265808.jpg

Hibabejelentés: (+36) 89/313-455 | Ügyfélszolgálat: (+36) 89/313-455 központi szám munkaidőben.| Email: info@papaivizmu.hu
Elérhetőségeink
Hibabejelentés: (+36) 89/313-455
Központ: (+36) 89/313-455
Ügyfélszolgálat: (+36) 89/313-455 központi szám
Mérőállás diktálás: (+36) 89/510-630
E-mail: info@papaivizmu.hu
HTTP sütiket (cookie) használunk, hogy a legjobb felhasználói élményt biztosítsuk!
Ha a "Rendben" gombra kattint, elfogadja, hogy sütiket (cookie) használjunk.